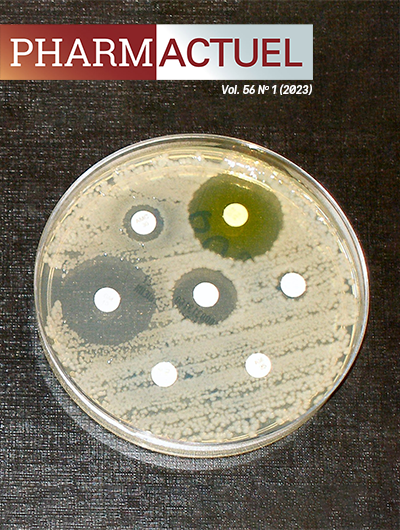

Étude ALTAR : l’hippurate de méthénamine est-il une solution de rechange efficace et sûre à l’antibioprophylaxie des infections urinaires récurrentes chez la femme?
Publié
Comment citer
Numéro
Rubrique
Licence
Les droits d’auteur de tout ce que contient Pharmactuel sont protégés par l’Association des pharmaciens des établissements de santé du Québec (A.P.E.S.). En soumettant leur manuscrit, les auteurs transfèrent, cèdent et, en d’autres termes, aliènent tous les droits qu’ils détiennent en vertu des droits d’auteur. Dès la publication du document, les auteurs doivent obtenir la permission de l’A.P.E.S. pour la reproduction de tout texte, figure, tableau ou illustration tirés de cet ouvrage dans un autre ouvrage de leur cru. Dans l’éventualité de la non-publication d’un manuscrit dans Pharmactuel, tous les dits droits seront abandonnés. L‘utilisation en tout ou en partie d’un article publié dans Pharmactuel doit être approuvée par l’A.P.E.S. Un formulaire d’autorisation concernant les droits d’auteur peut être obtenu en communiquant avec le coordonnateur de Pharmactuel à coordonnateur@pharmactuel.com.